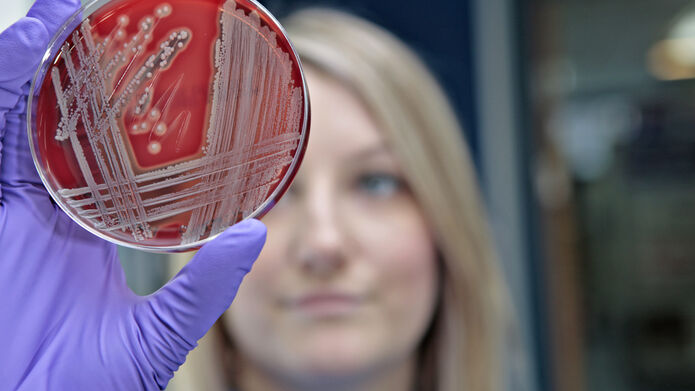
Microbiologist holding up petri dish with a pattern on it

Divisions, centres, and units in Life Sciences
The School of Life Sciences is structured into divisions, centres and units. This allows research groups studying similar topics to be grouped together to encourage collaboration and interdisciplinary working.

MRC-PPU (Medical Research Council Protein Phosphorylation and Ubiquitylation Unit)